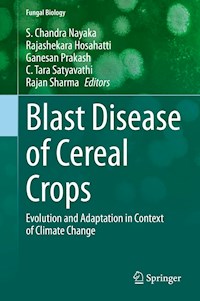
Blast Disease of Cereal Crops -  - E-Book

Blast Disease of Cereal Crops E-Book
0,0
149,79 €
149,79 €
-100%
Sammeln Sie Punkte in unserem Gutscheinprogramm und kaufen Sie E-Books und Hörbücher mit bis zu 100% Rabatt.
Mehr erfahren.
Mehr erfahren.
- Herausgeber: Springer International Publishing
- Kategorie: Wissenschaft und neue Technologien
- Serie: Fungal Biology
- Sprache: Englisch
Blast is an important foliar disease that infects the majority of cereal crops like rice, finger millet, pearl millet, foxtail millet and wheat, and thus resulting in a huge economic impact. The pathogen is responsible for causing epidemics in many crops and commonly shifts to new hosts. Magnaporthe spp. is the most prominent cause of blast disease on a broad host range of grasses including rice as well as other species of poaceae family. To date, 137 members of Poaceae hosting this fungus have been described in Fungal Databases.
This book provides information on all blast diseases of different cereal crops. The pathogen evolves quickly due to its high variability, and thus can quickly adapt to new cultivars and cause an epidemic in a given crop. Some of the topics covered here include historical perspectives, pathogen evolution, host range shift, cross-infectivity, and pathogen isolation, use of chemicals fungicides, genetics and genomics, and management of blast disease in different cereal crops with adoption of suitable methodologies.
In the past two decades there have been significant developments in genomics and proteomics approaches and there has been substantial and rapid progress in the cloning and mapping of R genes for blast resistance, as well as in comparative genomics analysis for resolving delineation of Magnaporthe species that infect both cereals and grass species. Blast disease resistance follows a typical gene-for-gene hypothesis. Identification of new Avr genes and effector molecules from Magnaporthe spp. can be useful to understand the molecular mechanisms involved in the fast evolution of different strains of this fungal genus. Advances in these areas may help to reduce the occurrence of blast disease by the identification of potential R genes for effective deployment.
Additionally, this book highlights the importance of blast disease that infects different cereal hosts in the context of climate change, and genomics approaches that may potentially help in understanding and applying new concepts and technologies that can make real impact in sustainable management of blast disease in different cereal crops.
Das E-Book können Sie in einer beliebigen App lesen, die das folgende Format unterstützt:
Veröffentlichungsjahr: 2021
0,0
Bewertungen werden von Nutzern von Legimi sowie anderen Partner-Webseiten vergeben.
Legimi prüft nicht, ob Rezensionen von Nutzern stammen, die den betreffenden Titel tatsächlich gekauft oder gelesen/gehört haben. Wir entfernen aber gefälschte Rezensionen.





























